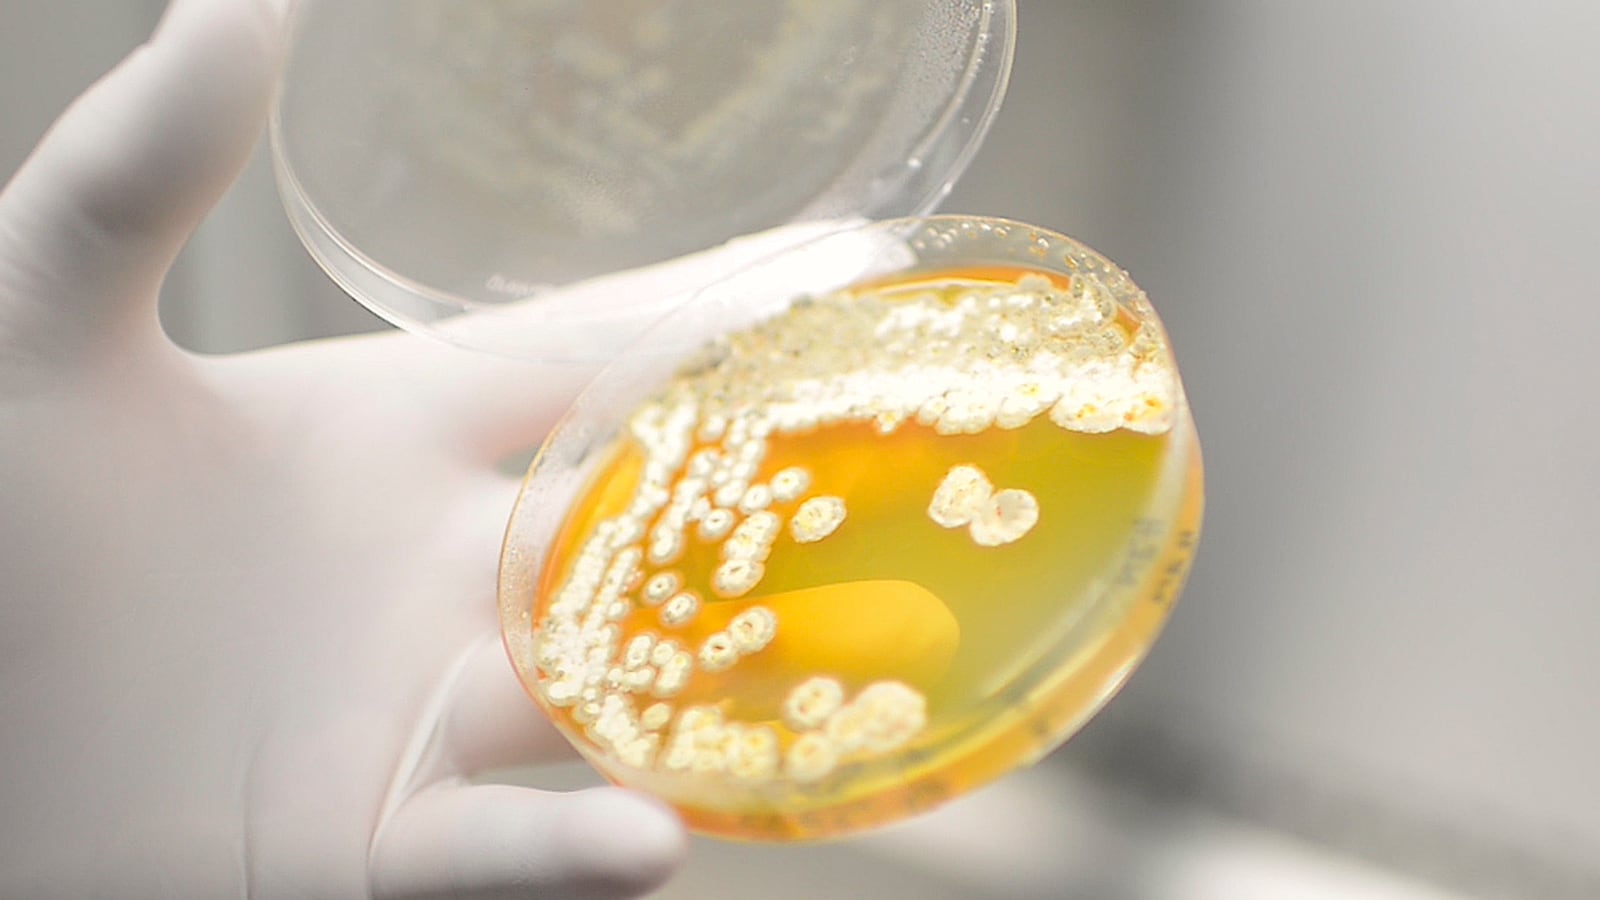

Décadas de estudio con las hormigas Apterostigma (familiares de las zompopas) dieron con una molécula que podría –en unos años– tener poder antibiótico y antifúngico para tratar infecciones comunes en los seres humanos y que atacan las uñas, boca, piel y otras zonas del cuerpo.
Este hallazgo fue hecho en suelo costarricense: en la Estación Biológica La Selva, en Sarapiquí (Heredia). Por esta razón, la molécula fue bautizada con el nombre de Selvamicina. Esta estación es parte de la Organización Para los Estudios Tropicales (OET).
Detrás de este hito destaca la labor del biólogo costarricense Adrián Pinto, quien lideró un equipo de científicos de diversas disciplinas de la Universidad de Costa Rica (UCR), en conjunto con la Escuela de Medicina de la Universidad de Harvard y de la Universidad de Wisconsin en Madison (EE. UU.).
De nuestro archivo: Antibiótico en hormigas ofrece esperanza para la Medicina
¿Cómo es que un grupo de hormigas puede dar con una solución para la medicina humana? Una relación de millones de años entre las hormigas, un hongo, unas bacterias y parásitos da la respuesta.
Todo se centra en cómo las Apterostigma obtienen su alimentación. Cuando vemos a una hormiga llevar hojas o ramas hacia su hormiguero, estas no son su comida, en realidad, son la materia prima para cultivar un hongo que es su principal fuente de alimentación. Sin embargo, la supervivencia de este hongo no es fácil, pues es amenazado por distintos parásitos.
Pero, allí mismo, en dónde está la solución: en ese hongo vive una bacteria del género Pseudoadina. Esta bacteria se aloja en la hormiga y de allí recibe su alimentación. A cambio, la bacteria genera una serie de sustancias antibióticas y antifúngicas que acaban con el parásito. De esta forma, el microorganismo no puede matar al hongo y las hormigas consiguen alimentarse.
Los científicos analizaron esta sustancia antibiótica –la Selvamicina– y vieron que podría servir para inhibir el crecimiento de la Candida albicans, hongo que en los humanos produce infecciones en la piel, uñas y boca. Los resultados de este descubrimiento fueron publicados en la última edición de la revista Proceedings of the National Academy of Sciences (PNAS).
"Hubo muchas cosas que observamos. En algunas de estas bacterias la sustancia antibiótica está en los cromosomas como es lo usual, pero en otras, está en los plásmidos (moléculas de ADN que no se encuentran en los cromosomas, si no en el citoplasma de algunas bacterias). Los plásmidos son usualmente la salida que encuentran los microorganismos para volverse resistentes. Pero, si el antibiótico está en los plásmidos, el agente invasor muere y no puede generar la resistencia. Tal vez es por eso que este poder antibiótico lleva millones de años en las hormigas y nuestros antibióticos ya muestran problemas de resistencia después de solo 70 años", explicó Pinto, quien fue Premio Nacional de Ciencia en el 2010.
Aporte vital
Este desarrollo científico es de vital importancia para la medicina moderna, pues cada vez cuesta más encontrar antibióticos.
Entre los principales problemas que afrontan los sistemas de salud pública está el que estos microorganismos, en su lucha sobrevivir, buscan fortalecerse; con esto se hacen resistentes a tratamientos médicos. Es decir, llegaría el momento en que los fármacos tradicionales no combatirían la infección.
"Uno de los mayores desafíos de la medicina moderna es que cada vez tenemos bacterias y microorganismos resistentes a los antibióticos y se necesitan nuevas opciones para que las enfermedades no se queden sin tratamientos. Esta es la razón por la cual es tan importante el hallazgo, porque encontró, en un lugar diferente, una posible solución", comentó Fernando García, vicerrector de investigación de la UCR.

Pinto agregó: "sabíamos que teníamos que buscar caminos diferentes para llegar a los nuevos antibióticos, la naturaleza misma nos da las respuestas, por eso es clave el estudio de la microbiología ambiental".
Por su parte, Carlos de la Rosa, director de la Estación La Selva se mostró complacido: "el que el compuesto se llame Selvamicina es todo un honor, no solo por ser el nombre de nuestro lugar, también es un tributo a la naturaleza como fuente de soluciones para la salud".

Para Ethan van Arman, uno de los investigadores de la Escuela de Medicina de Harvard, el aporte es "muy rico".
"La Selvamicina puede ser una gran respuesta. En nuestro trabajo nos intrigaba la inusual estructura química de esta molécula y la forma en la que mata muchos hongos; de ellos, algunos que afectan mucho la salud humana", aseveró.
¿Qué sigue? Este descubrimiento es solo el principio de años de investigación.
"Sigue el Valle de la Muerte", comentó Pinto entre risas.
"La mayor parte de las moléculas no consiguen pasar las pruebas antes de convertirse en un producto. Falta, falta mucho. Ver el alcance del poder antibiótico, análisis de toxicidad, de seguridad, ver las posibles dosis y cómo actúa en el cuerpo. Sin embargo, ya solo este descubrimiento es algo inmenso", añadió.
Usualmente, entre el momento en que una molécula se descubre y el medicamento está a disposición del público, pasan unos diez años. Y esto solo sucede si el compuesto consigue vencer todos los procesos.
Mas Pinto se muestra esperanzado: "este descubrimiento ya nos dio un primer resultado y muy bueno: el que ya haya un convenio con las universidades de Harvard y de Wisconsin (donde este científico ya había realizado estudios y colaboraciones) para que nuestros científicos puedan ir a capacitarse en microbiología ambiental".
Jon Clardy, uno de los investigadores de la Universidad de Harvard, opina parecido: "queda todavía un largo camino, desde la etapa en la que nos encontramos hasta llegar a algo que ayude a las personas, pero ya comenzamos el proceso", concluyó.
